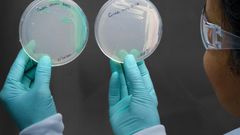

The physician said the fungus was called Candida auris, and it appeared to have entered her bloodstream through a catheter or other intravenous line during her treatment. Spoor sent a text to the couple’s four children.
“Hey guys, I’m very sorry to do this via text but you need to know and not fair to wait until all of us are together,” he wrote. “The fungus mom has is the worst possible and can be terminal.”
He added: “It is a day to day issue so I don’t have any more answers or info at this time.”
Gregory Spoor, 67, an executive at a plumbing equipment company, wasn’t the only one with few answers. C. auris, a germ that typically is resistant to major anti-fungal medications, has been quietly confounding doctors, hospitals and infectious disease scientists around the world.
First identified in the ear of a woman in Japan in 2009 (“auris” is Latin for “ear”), the germ has spread around the globe, mostly appearing in hospitals and nursing homes, where it afflicts people with weakened immune systems.
Nearly 600 cases of C. auris have been reported in the United States, the majority of them in New York, New Jersey and Illinois. According to the Centers for Disease Control and Prevention, nearly half of people who contract the illness die within 90 days. But the true death rate is difficult to quantify because most patients have other medical conditions and their deaths may be attributed to other causes.
About 90 percent of C. auris strains are resistant to at least one drug, and 30 percent are resistant to two or more of the three major classes of anti-fungal drugs. However, Tuesday, the CDC confirmed that it has learned in the last month of the first known cases in the United States of so-called “pan-resistant” C. auris — a strain resistant to all major antifungals, said Dr. Tom Chiller, head of the agency’s fungal division, in an interview.
Such cases have been seen in several countries, including India and South Africa, but the two new cases, from New York state, have not been reported previously. Chiller said that it appeared that, in each case, the germ evolved during treatment and became pan-resistant, confirming a fear that the infection will continue to develop more effective defenses.
“It’s happening, and it’s going to happen,” Chiller said. “That’s why we need to remain vigilant and rapidly identify and control these infections.”
It often has been hard to gather details about the path of C. auris because hospitals and nursing homes have been unwilling to publicly disclose outbreaks or discuss cases, creating a culture of secrecy around the infection. States have kept confidential the locations of hospitals where outbreaks have occurred, citing patient confidentiality and a risk of unnecessarily scaring the public.
Stephanie Spoor’s family contacted The New York Times to share details of her case after reading an article in the newspaper about the emergence of C. auris and the growing threat of drug-resistant infections. Her experience sheds some light on the experience of dealing with the new health threat.
Northwestern Memorial has not issued any public announcement that it had cases of C. auris. The Illinois Department of Public Health confirmed Spoor’s case after the family gave officials permission to discuss it with The Times. But it would not disclose the identities of what it called “numerous” hospitals and nursing homes that have reported a total of 158 cases in the state since 2016.
Northwestern Memorial declined to answer any questions from The Times about Stephanie Spoor’s case, despite receiving permission from the Spoor family to cooperate.
The hospital also declined to respond to questions about how many C. auris cases it has treated, whether there were any current cases, what precautions it was taking and other queries.
“After careful consideration, we are going to pass on participating in this story,” Christopher King, a hospital spokesman, wrote in an email in response to questions.
Generally, health care institutions have said that they do not want to worry the public unnecessarily, given that they are working hard to control the spread of the infection and also that the germ is not a health threat to the general public. The people at the greatest risk are those who have compromised immune systems, typically through illness and age, and who are in hospitals and nursing homes where many infections are carried and transmitted.
Stephanie Spoor’s tale reveals the powerlessness of patients and institutions in the face of resistant infections.
Late last year, Spoor began experiencing shortness of breath and appeared to be having a surge of symptoms from lupus, an autoimmune disorder she had been diagnosed with years earlier but which did not seem to disrupt her daily life. Now, her lungs were having trouble absorbing oxygen.
Spoor’s family kept a detailed diary of the events, at her request. She went to Northwestern Memorial Hospital, a highly ranked academic medical center affiliated with Northwestern University. There, in mid-December, she had a biopsy that led to complications: The wound bled, and she went into cardiac arrest. She was revived and put on a device called an extracorporeal membrane oxygenation machine to help her breathe.
That machine was considered a way station to help Spoor survive until she could receive a lung transplant. She felt hopeful she would be able to see her youngest son, Zack, get married in a ceremony planned for June.
But a month later, a blood test found C. auris. Stephanie Spoor’s medical records, which the family shared with The Times, contained a note in mid-January in bold type: “This is a highly transmissible fungus that has a propensity to develop resistance.” The records continued, again in bold type, that it was necessary to “discuss with nurses to maintain diligent contact precautions and limited visitors if possible.”
Those records indicated that the hospital suspected Spoor picked up the infection from one of the tubes inserted into her body.
Spoor’s son Nicholas, 40, a Chicago architect, said that the day his mother was diagnosed with C. auris, he noticed the nurses and doctors in full protective aprons and gloves, using bleach to wipe off their feet when they entered and left the room. Everything in the room had a white glaze, he said, from the chemicals used to clean it.
“It was like a laboratory,” he said.
But the family was hopeful. A doctor told them, Nicholas Spoor called, “that the strain they had had at Northwestern had been susceptible to the drug cocktail they were currently giving her, and they expected it to clear up.”
Indeed, according to the medical records, initial lab tests suggested that the strain of C. auris that had infected Stephanie Spoor’s bloodstream was susceptible to the hospital’s drug treatment.
The records also included hints of doubt. “Limited literature on C. auris indicates a relatively high mortality and this pathogen may be difficult to eradicate,” a Jan. 19 notation said.
Over the latter half of January, doctors and nurses furiously tried to treat the fungus, but it kept growing back. The drugs weren’t working. Spoor appeared fatigued, the family said, but was not showing any other particular obvious signs of infection.
Barely two months earlier, before her biopsy, Spoor had been thrilled to accept an early Christmas present from the family: She attended a speech by Michelle Obama at the United Center in downtown Chicago.
Now, in the early days of February, she and her family were being told to put her affairs in order. A doctor told Spoor that there was nothing more to be done. A transplant wasn’t realistic until she was clear of C. auris, but there seemed to be no effective treatment for the infection.
On February 8, their grief was suspended briefly, and the atmosphere in her hospital room turned celebratory. The Spoors’ youngest son, Zack, married his fiancee, Carley, in a wedding ceremony at her bedside.
Bride and groom wore protective blue hospital gowns over their formal wear, and blue gloves. After the chaplain pronounced them husband and wife, said a blessing and an “Amen,” Stephanie Spoor grinned as if she had beat the devil at cards.
A few days later, after consulting with the family, doctors removed Spoor from the oxygenation machine — her life support, essentially.
In the hours before, Spoor said there was one last person she’d like to speak with: her son Nicholas, with whom she had not yet had a final heart-to-heart conversation.
“She just said what you’d expect a mom to say to you in that situation,” Nicholas Spoor recounted. He tried to elaborate, but began to cry: “I can’t talk about it. She just said the exact right thing.”
Stephanie Spoor died Feb. 11. Her death certificate describes the cause as respiratory failure.
Dr. Rosalind Ramsey-Goldman, a rheumatologist who treated Spoor, said she felt for the family. “Understandably, her family has had a hard time dealing with their loss,” she said “And as providers, we too were saddened by the events that transpired, and that we were not able to help her when she had this infection.”
Spoor’s husband, Greg, said he bears no grudge against the hospital and, in fact, found its care exceptional. He said he wished that he had known to ask about C. auris and the precautions the hospital was taking.
“It was something that we didn’t even know was out there, and then it happened, and it was one of the major reasons she died,” said her son Nicholas. “If you’re not sharing the data about the patients, that’s an issue.”
This article originally appeared in The New York Times.

&format=jpeg)
&format=jpeg)
&format=jpeg)
&format=jpeg)